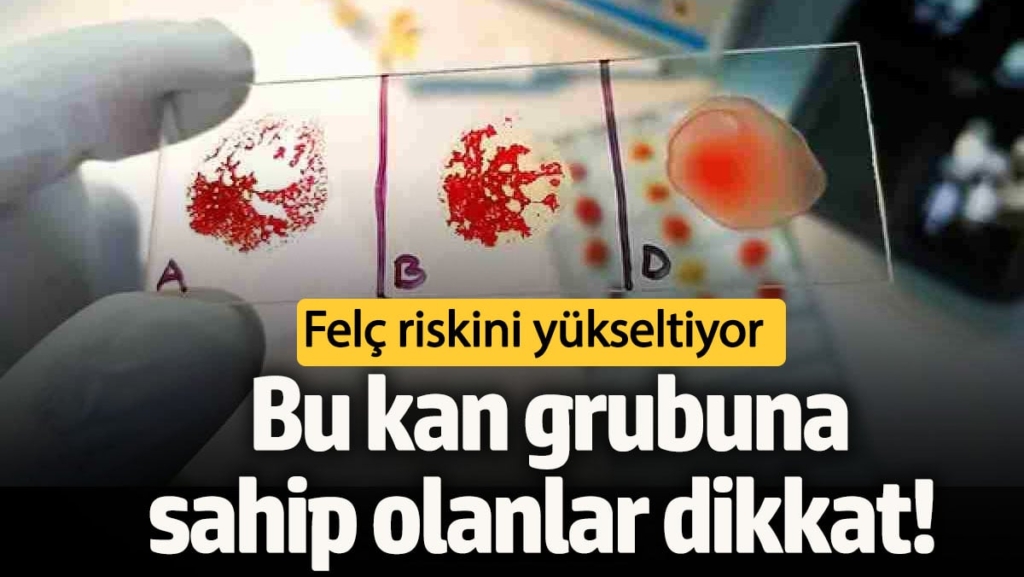
featured

Kan Grupları ve Felç Riski Araştırması
A ve B olarak bilinen kan grupları, birlikte AB olarak, tek başına A ya da B olarak veya hiç bulunmayarak O grubu olarak sınıflandırılıyor.

2022 yılında gerçekleştirilen bir araştırmada, bilim insanları A1 alt grubuna ait gende erken yaşta felç geçirme riskinin bulunduğunu ortaya koydu. Bu çalışma, yaklaşık 17 bin felç vakası ile 600 bine yakın felç geçirmemiş bireyi içeren 48 genetik çalışmanın verilerini analiz etti. Araştırmaya katılanların yaş ortalaması ise 18 ile 59 arasında değişiyor.

Risk Haritasında Dikkat Çeken Farklar
TRT Haber’in aktardığı sonuçlara göre, A grubuna ait genetik varyasyonu taşıyan bireylerin 60 yaşından önce felç geçirme riski, diğer kan gruplarına sahip bireylere oranla yüzde 16 daha yüksek. Diğer yandan O grubu gen varyasyonuna sahip bireylerde ise bu risk yüzde 12 daha düşük olarak belirleniyor.

Araştırmanın baş yazarı ve vasküler nörolog Steven Kittner, “A kan grubunun neden daha yüksek bir risk sunduğunu henüz bilmiyoruz.” ifadelerini kullanarak, kan pıhtılaşma faktörleri, kan damarlarını kaplayan hücreler ve dolaşımdaki proteinlerle ilgili olabileceğini belirtti.